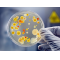
Optides Rico

QAC Based Cleaner and Germicide;
OPTIDES RICO is an excellent QAC-based product specially formulated for cleaning water-resistant surfaces, removing dirt, oil, and microorganisms.
It is effective against Gram-negative and Gram-positive microorganisms, Candida albicans, Pseudomonas aeruginosa, Pneumoniae, Staphylococcus aereus, Escherichia coli, Mycobacterium smegmatis, Aspergillus niger, Legionella pneumphila, Klebsiella Salmonella typhi, Shigella dysentaria, Bacillus cereus, Alpha-hemolytic streptocci, molds, yeasts, fungi, and protozoa.
It is safe for use in high-traffic areas such as schools, hospitals, and Turkish baths, for cleaning surfaces frequently touched by hands, and for the interior cleaning and hygiene of public transportation vehicles such as buses, minibuses, trains, ships, and subway cars. It is safely used to eliminate unpleasant odors in cold storage areas where meat, milk, cheese, and ice cream are stored, and for the general cleaning and hygiene of all animal barns, from ceiling to floor, including large and small livestock farms.
It is safely used for air conditioning hygiene, neutralizing deadly legionella bacteria found in air conditioner filters, general cleaning of drinking and utility water tanks, and eliminating bacterial and legionella virus growth on faucet spouts.
INSTRUCTIONS FOR USE
Spray and wipe the surface to be cleaned and disinfected with a mixture of OPTIDES RICO diluted in water. Rinsing is not required. However, surfaces that will come into contact with food should be rinsed before use.
USE DOSAGE
A 1-2% solution is prepared and used depending on the intensity of the contamination.
| PRODUCT CODE | WEIGHT | PIECE | FORM |
| EH2324665 | 5 | 3 | LIQUID |
| EH2324662 | 20 | 1 | LIQUID |
| EH23246610 | 1000 | 1 | LIQUID |
Brand: Optimal
A deburring product suitable for iron, copper and brass surfaces with surface cleaning and polishing properties. Please contact our technical team for detailed information.